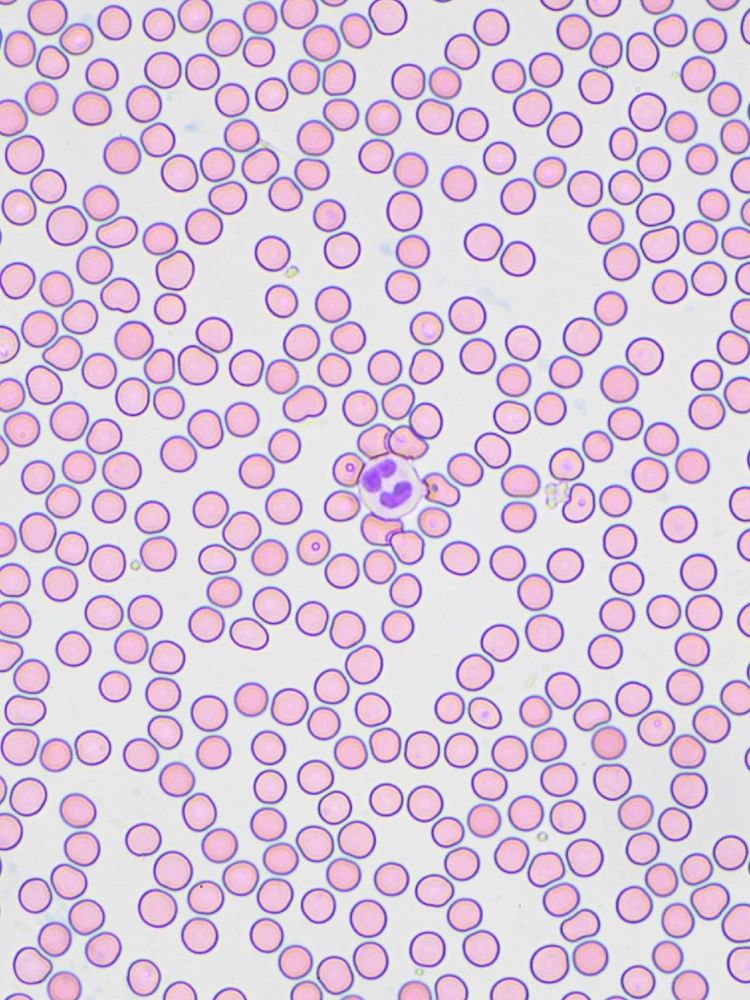
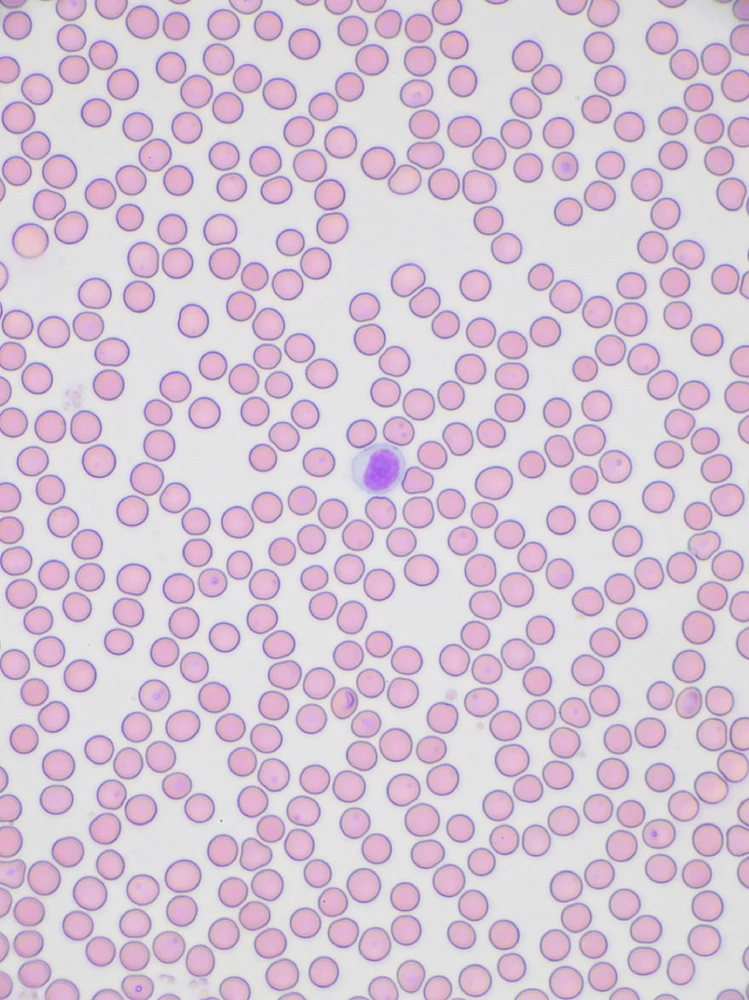
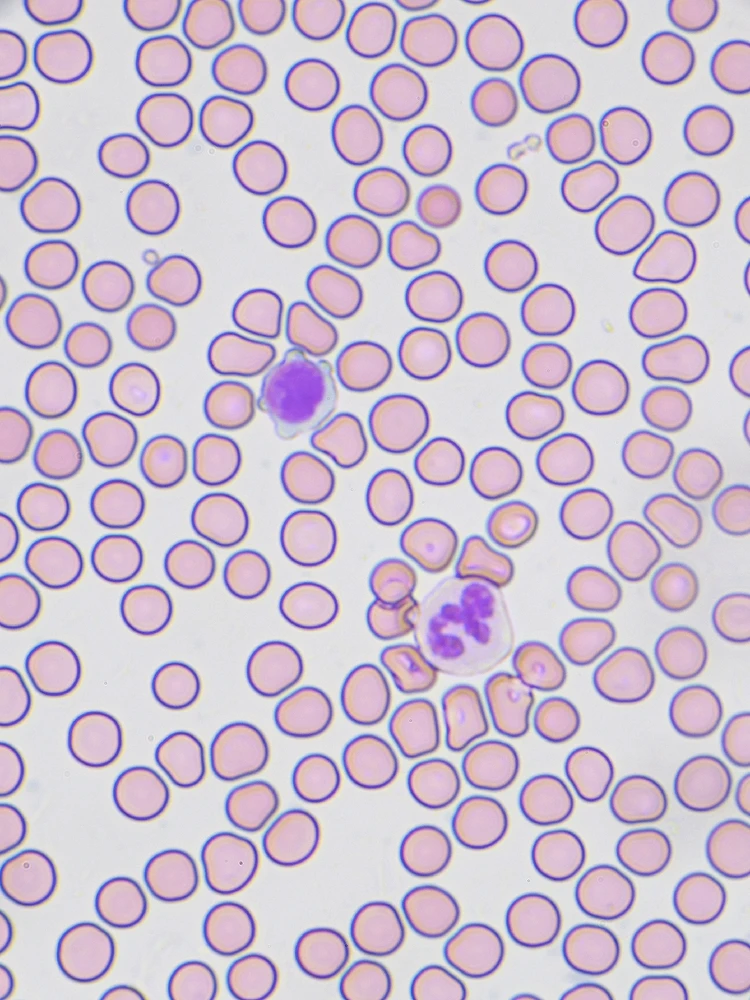
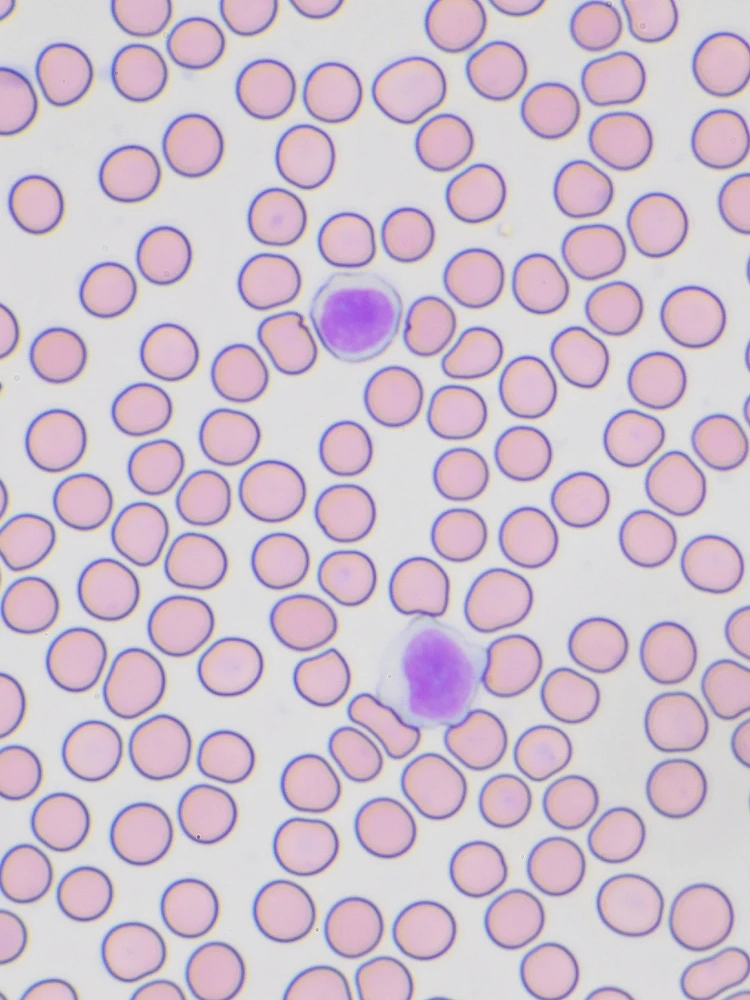

Сообщество Microscopy
microscopy: сообщество, общение и обсуждение.
81 душ
81 душ
6мес
ENFP
Лев
Крыло совки под микроскопом
Испытал осветитель микроскопа для исследования в отражённом свете. В качестве образца крыло дохлой совки😁. Размер чешуек порядка 50-150мкм. Фокусный стек, объектив Infinity plan 10x🔬🦋



9
0
10мес
ENFP
Лев
Кровь под микроскопом
Решил поближе рассмотреть мазок крови👻🤩🔪 Фиксатор - раствор по Май-Грюнвальду, краситель - Азур-эозин по Романовскому. На фотках хорошо видны различные лейкоциты (нейтрофилы, лимфоциты) Увеличение ≈600x-1000x🔬

2
2
1г
ENFP
Лев
Пыльца ивы, стек, объектив infinity plan 20x

20
4
1г
ENFP
Лев
Глаз муравья жнеца под микроскопом, фокусный стек.

21
7
1г
ENFP
Лев
Амеба, ускорено в 5 раз
17
3
1г
ENFP
Лев
Кристаллы лимонной кислоты в поляризованном свете

17
0
Знакомься с новыми людьми
50 000 000+ СКАЧИВАНИЙ